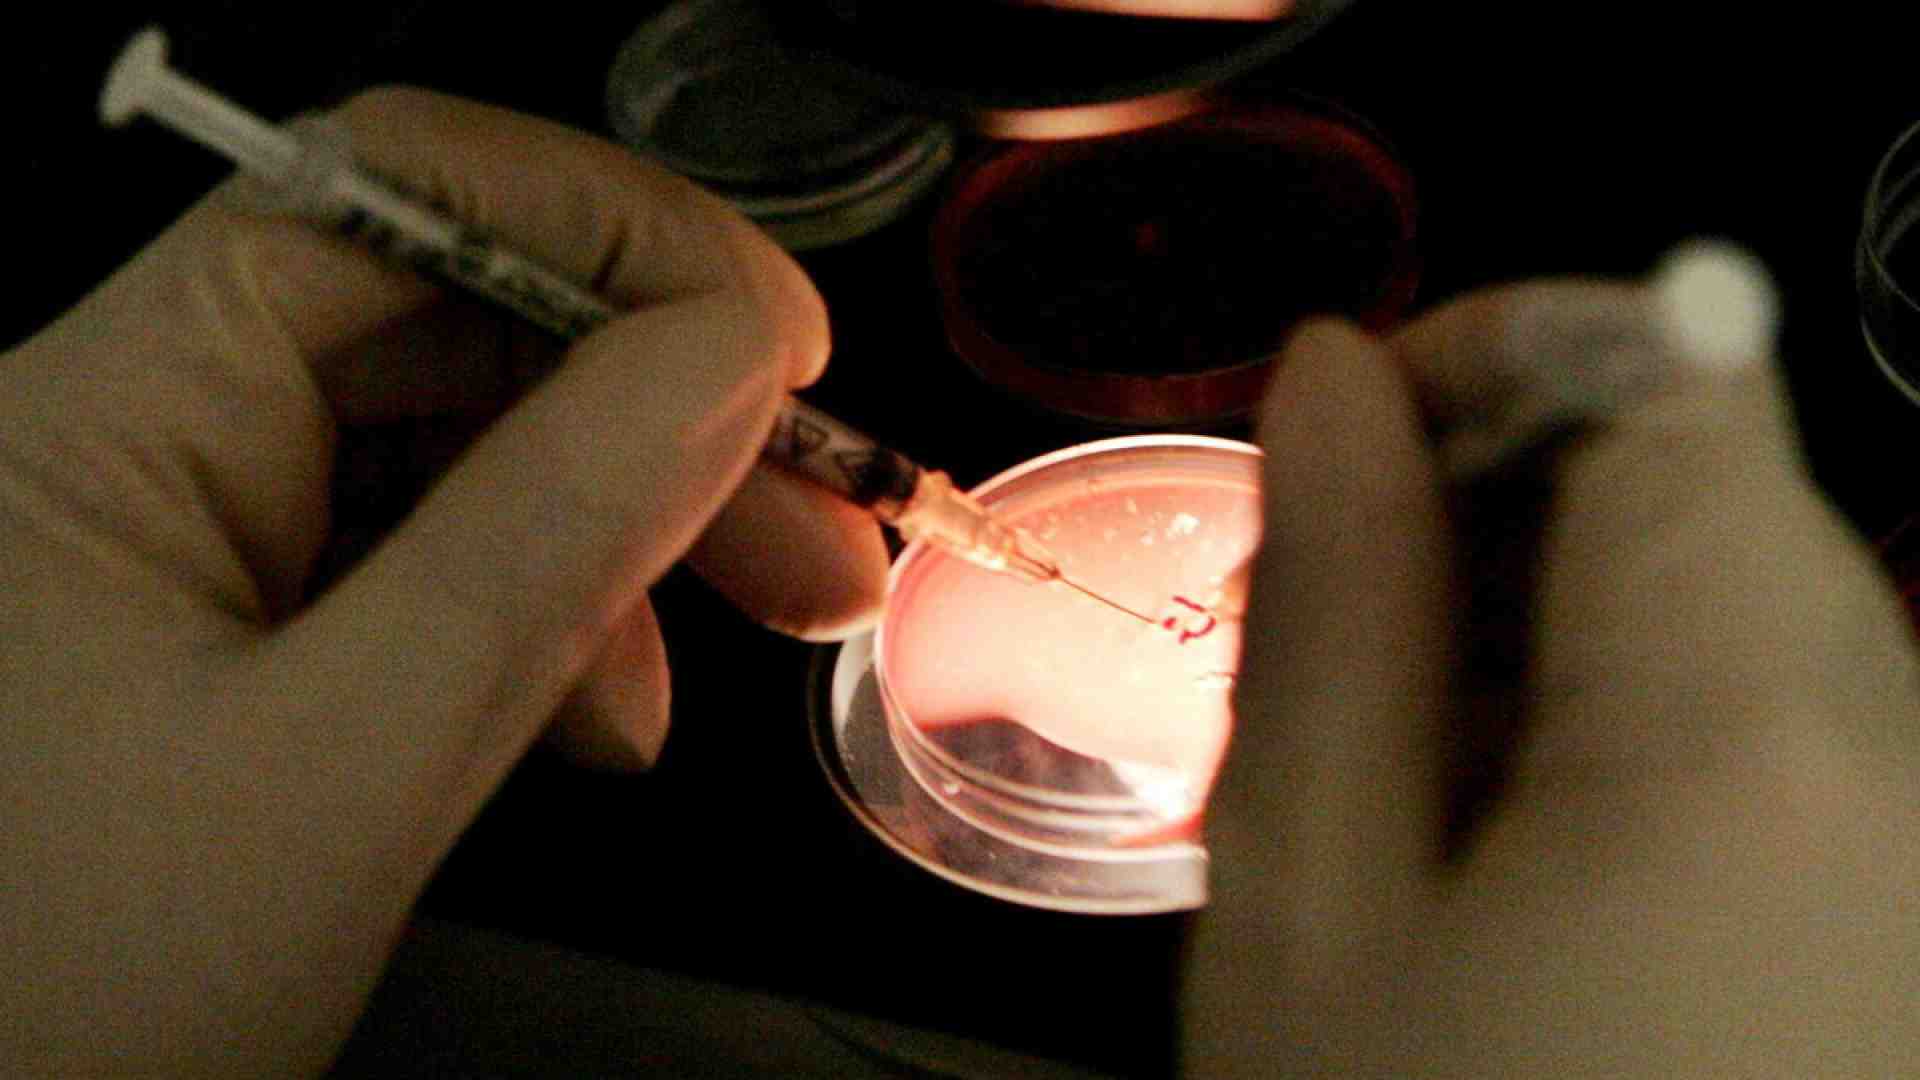

Se il welfare aziendale predica la crio-conservazione degli ovociti
Dario Di Vico
01/20/2026
Il giuslavorista laico Maurizio Del Conte, ex ministro del Lavoro, è perplesso. Il docente di Filosofia morale e Bioetica alla Cattolica, Alessio Musio, è decisamente contrario. E anche dai sindacati sono arrivati rilievi e critiche. Otb, Only the brave, è una multinazionale tascabile veneta dell’abbigliamento che fa capo a Renzo Rosso e i suoi marchi più famosi sono Diesel e Jil Sander. Ha una tradizione di welfare aziendale con un’attenzione spiccata alla diversità e all’inclusione. Ed è proprio l’ultima sua iniziativa in ordine di tempo a far discutere: un progetto di formazione sul tema della fertilità che comprende anche la crio-conservazione degli ovociti. E’ rivolto alle dipendenti del gruppo con età compresa tra i 30 e i 40 anni ed è finanziato interamente dall’azienda. A oggi negli ospedali pubblici italiani la conservazione al freddo degli ovociti si può richiedere solo in presenza di gravi patologie mentre nella sanità privata costa dai 3 ai 7 mila euro. Il welfare aziendale finora era stato criticato solo dai puristi del Servizio sanitario nazionale perché a dir loro crea disparità, ora invece viene contestato per la prima volta per motivi etici. Un salto di qualità che, volendo, può rappresentare anche l’occasione di un sano dibattito pubblico.
La novità è recentissima e a renderla nota è stata Arianna Alessi, presidente della Otb Foundation e moglie di Rosso, che l’ha collocata dentro all’offerta di diversi servizi per la genitorialità, dall’asilo nido interno alla flessibilità lavorativa con l’idea di “favorire l’uguaglianza di genere” e “garantire che le decisioni sulla maternità siano sempre più libere e individuali”. Il social freezing – così viene definita la crio-conservazione degli ovociti –, secondo Alessi prevede in Italia tempi troppi lunghi, rendendo la pratica “un privilegio per pochi” che devono per forza ricorrere a operatori privati con esborsi elevati. Per questo motivo la Otb Foundation in continuità con la sua visione welfare oriented del rapporto con i dipendenti “intende attivare questa ulteriore iniziativa impegnandosi a finanziare i percorsi per le colleghe del gruppo che aderiranno”. L’obiettivo è promuovere la libertà di scelta sulla propria vita riproduttiva, contrastare l’infertilità legata all’età e “offrire soluzioni a un’evoluzione sociale e lavorativa che spesso posticipa il desiderio di maternità”. Per implementare quest’offerta, Alessi e Rosso hanno stipulato una convenzione con un gruppo, Genera, che opera nella procreazione medicalmente assistita. Sostiene infatti Laura Rienzi, direttore scientifico del gruppo, che il social freezing può essere considerato per alcune persone una delle opzioni possibili in un contesto di vita e di lavoro in evoluzione.
Tutto bene dunque? Il welfare aziendale si appresta a fare un passo in avanti nel rapporto con i dipendenti, creando uguaglianza di trattamenti uomo-donna a costo di entrare in una sfera di scelte molto privata? Secondo quando ha scritto il Corriere del Veneto ai sindacati l’iniziativa non è piaciuta, anzi l’hanno bocciata. Il giornale riporta la presa di posizione di Riccardo Colletti, dirigente della Filctem-Cgil secondo il quale per agevolare davvero la genitorialità l’azienda dovrebbe dare garanzie di tutela della professionalità della lavoratrice al rientro dalla maternità oppure un più agevole accesso al part time, argomenti rispetto ai quali Otb è stata sempre restia a negoziare. “Sono queste le condizioni preliminari alla maternità presenti in altre aziende come Luxottica e non a caso in quel contesto l’idea della crio-conservazione non viene in mente a nessuno”. Perplesso, come detto, è anche il giuslavorista Del Conte. “In questo modo si dà per scontato che se vuoi far carriera devi avere figli in un tempo rinviato. C’è un nesso inscindibile con la prestazione lavorativa e il messaggio che arriva alle giovani è di aspettare i 40 anni. E’ qualcosa di molto diverso da quanto accade in altri paesi”. Del Conte riconosce che è giusto aggiornare gli istituti di welfare al mutato contesto sociale, “ma piuttosto che la crio-conservazione le aziende dovrebbero dare strumenti di conciliazione vita-lavoro”. E non ultimo, l’azienda si inserisce in una decisione personale “con una generosità che suona sospetta”.
Ancor più critico il docente di Bio-etica della Cattolica, Musio. “Così si distrugge il welfare aziendale. Non si pagano delle cure ai dipendenti ma si fagocita la generazione dei figli in una logica che non può che apparire produttivistica. La maternità viene differita nel tempo per non ostacolare i ritmi della produzione e la scelta di generare figli viene appaltata alla tecnica”. C’è, per Musio, una evidente subordinazione dell’umano al mercato. “Lo chiamano social freezing ma è proprio la dimensione sociale del welfare a essere congelata. Così si sconta un’immagine alla Amazon ma prelevare gli ovociti non è come ordinare un pacco, è un’operazione chirurgica invasiva”.

